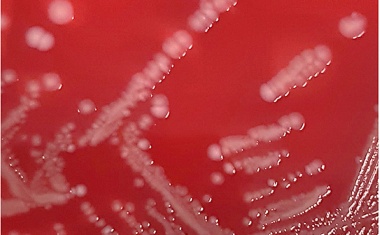
Photo

UKJ-Erfahrungen in neuer S3-Leitlinie zur Antibiotika-Therapie verankert
Am Uniklinikum Jena etablierte klinische Standards sind jetzt bundesweite Fachempfehlung für die Behandlung von Infektionen mit multiresistenten Erregern.

Am Uniklinikum Jena etablierte klinische Standards sind jetzt bundesweite Fachempfehlung für die Behandlung von Infektionen mit multiresistenten Erregern.

Am Universitätsklinikum Frankfurt am Main trat 2023 eine systemische P. aeruginosa Trinkwasserkontamination auf. Als wahrscheinliche Kontaminationsquelle wurde ein Wasserzähler identifiziert.

Sarah Faucheux übernimmt die Leitung der Stabstelle Hygiene am Klinikum St. Georg.

Die Krankenhaushygiene schützt vor nosokomialen Infektionen. Gleichzeitig verursacht sie ökologische und ökonomische Effekte.

Weg vom Image der „Hygiene-Polizei“: Der weltweit erste und bisher einzige Hygiene-Kanal verändert die Kommunikation auf Social Media.

Hygiene und Nachhaltigkeit: Ein Thema für alle Krankenhäuser

„Die Stärkung des Infektionsschutzes ist eine wichtige Aufgabe. Die Prävention muss dabei an erster Stelle stehen“, sagte Dr. Ute Teichert, Leiterin der Abteilung Öffentliche Gesundheit im Bundesgesundheitsministerium, auf dem 13. Hygieneforum des Bundesverbandes Medizintechnologie am 12. Dezember 2024.

Lalita Ramakrishnan ist am Freitag, 8. November 2024 in Berlin mit dem mit 120.000 Euro dotierten Robert-Koch-Preis ausgezeichnet worden.

Zum 1. Oktober 2024 übernimmt Univ.-Prof. Dr. Frank Günther die Leitung der Abteilung für Hygiene und Infektionsprävention an der Universitätsmedizin Mainz.

Prozessoptimierung in der Sterilgutaufbereitung: Ein Balanceakt zwischen Präzision und Wirtschaftlichkeit

Das Evangelische Amalie Sieveking Krankenhaus in Hamburg-Volksdorf ist mit der höchsten Auszeichnung der bundesweiten „Aktion Saubere Hände“ – dem Zertifikat in Gold - ausgezeichnet worden.

Dr. Meike Laatzen ist neue Leitende Oberärztin der Abteilung.

Die Abteilung für Krankenhaushygiene am Universitätsklinikum Marburg startet zusammen mit OPHARDT Hygiene und B. Braun Deutschland eine umfangreiche Studie zur Händehygiene.

Hygiene-Preis und Verleihung der Hygieia Medaille der Rudolf Schülke Stiftung

Ende Februar lud das Institut für Medizinische Mikrobiologie und Krankenhaushygiene des Klinikum Region Hannover zum 2. Hygiene Update in das Konferenzzentrum des KRH Klinikum Siloah ein.

Am Universitätsklinikum Schleswig-Holstein (UKSH) haben neue Führungskräfte ihre Ämter angetreten.

Der Fachbereich Gesundheit der Stadt Mönchengladbach hat die Städtischen Kliniken Mönchengladbach jetzt als erstes Krankenhaus in Mönchengladbach für die Bekämpfung von multiresistenten Erregern (MRE) mit dem LZG-Siegel zertifiziert.

AMS-MAN: Mainfränkisches Antimicrobial Stewardship Netzwerk wächst weiter.

Die Paracelsus-Kliniken untersuchen Verbesserungsmöglichkeiten beim schnellen Erkennen und Behandeln von Sepsen.
Dr. Volker Winstel möchte mit seiner Forschung neue Therapieoptionen bei Infektionen mit Staphylococcus aureus erschließen.

Ausbruchsmanagement erhöht die Sicherheit von Patienten und Mitarbeitern und trägt zur Aufrechterhaltung der öffentlichen Gesundheit bei.

Prof. Dr. Stefanie Kampmeier wird zum 1. Juli neue Professorin für Krankenhaushygiene an der Würzburger Universitätsmedizin.

Hands-on und Händehygiene

Die Stiftung „Viamedica – Stiftung für eine gesunde Medizin“ begeht anlässlich ihrer Gründung im Dezember 2002 ihr 20-jähriges Jubiläum. Als neutrale Plattform hat sie in den letzten Jahren viel bewegt, um das Gesundheitswesen auf ihrem Weg zu mehr Nachhaltigkeit zu unterstützen.

Gewässer besser vor Mikroschadstoffen und Resistenzgenen schützen

Prof. Dr. Stephan Harbarth ist mit dem mit 50.000 Euro dotierten Robert-Koch-Preis für Krankenhaushygiene und Infektionsprävention 2022 ausgezeichnet worden.

Ärzte, Hygiene- und Umweltmediziner, Gesundheits- und Krankenpfleger mit der Weiterbildung zur Hygienefachkraft, Hygienebeauftragte und Gesundheitsaufseher werden vom Institut für Hygiene, Krankenhaushygiene und Umweltmedizin am Universitätsklinikum Leipzig zu den Krankenhaushygienetagen eingeladen.

Ein neues Weiterbildungsformat schließt die Lücke zwischen Wissenschaft und medizinischem Krankenhausalltag zur Stärkung der Patientensicherheit.

Der mit 50.000 Euro dotierte Preis wird am 6. September in Berlin verliehen.

Die Sepsis-Kampagne der Paracelsus Kliniken hat den zweiten Platz beim alljährlichen Wettbewerb "Hygiene medial vermitteln" der Deutschen Gesellschaft für Krankenhaushygiene gewonnen.

Prof. Jantsch übernimmt Institutsleitung.

Am Universitätsklinikum Gießen wird zum 1. April dieses Jahres eine neue Klinik entstehen, die Klinik für Innere Medizin mit Schwerpunkt Infektiologie und Krankenhaushygiene.

Mikrobiologie und Krankenhaushygiene haben wachsende Bedeutung für die Patientensicherheit.

Dr. Tim Götting koordiniert künftig die Krankenhaushygiene der Region Süd-West der Klinikgruppe.

Zunehmende Anwendungsdauern von endständigen Sterilfiltern werden von der KRINKO kritisch hinterfragt. Erhöhte Produktanforderungen sind notwendig, um die Patientensicherheit zu gewährleisten.

























